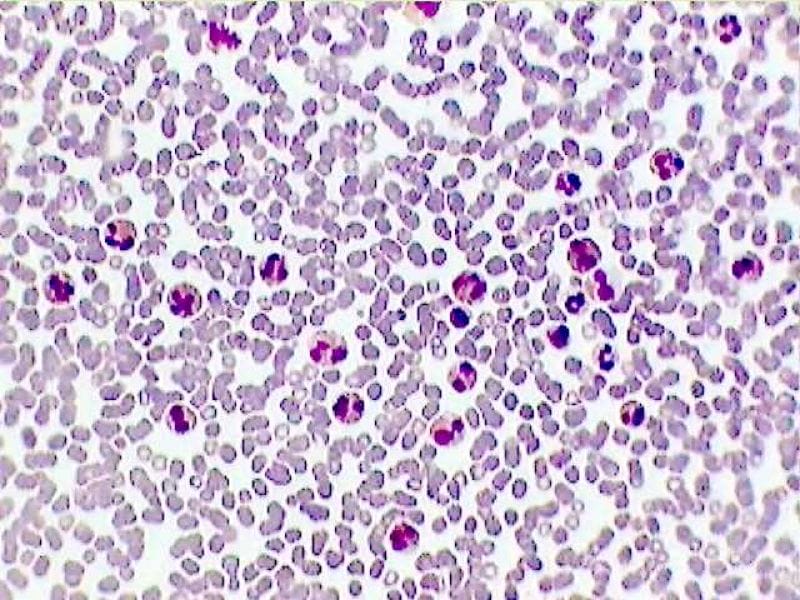

Mandi bisa dikatakan adalah sebuah aktivitas yang dianjurkan setiap hari tentunya. Dengan mandi, tubuh kita bisa terbebaskan dari kotoran-kotoran yang menempel dari tubuh. Selain itu, tentu dengan mandi secara rutin bisa menjaga kesehatan tubuh kita.
Biasanya mandi dilakukan dua kali sehari, yakni pada pagi hari dan sore hari. Namun terkadang, ada sebagian orang yang mandi sebelum subuh loh. Alasannya adalah karena mandi sebelum subuh banyak sekali manfaatnya untuk kesehatan. Lantas, apa saja sih manfaat-manfaatnya tersebut? Yuk, simak dengan seksama.
Meningkatkan Sel Darah Putih
Sel darah putih sangat bermanfaat bagi tubuh karena bisa menjaga kekebalan tubuh supaya bisa terhindar dari serangan penyakit. Nah, mandi sebelum subuh ternyata bisa meningkatkan sel darah putih loh. Oleh karena itu, jika kamu ingin tidak cepat sakit dan memiliki daya tahan tubuh yang bagus, mulai rutinkanlah mandi sebelum subuh.
Mandi sebelum subuh ternyata sering dilakukan juga oleh orang-orang zaman dahulu. Coba saja kamu tanyakan kepada orang yang sudah lanjut usia namun memiliki kesehatan fisik yang masih prima, rata-rata mereka waktu mudanya sering mandi sebelum subuh.
Memperbaiki Jaringan Sel Tubuh

Meningkatkan Kesuburan

Untuk para wanita, jika kamu ingin subur dan memperoleh banyak keturunan, maka kamu tidak perlu lagi mengkonsumsi berbagai macam obat. Hal sederhana ini ternyata bisa meningkatkan kesuburan wanita, yakni dengan membiasakan mandi pagi sebelum shubuh.
Banyak penelitian ilmiah yang mengatakan bahwa mandi pagi sebelum subuh mampu meningkatkan hormon estorgen pada wanita dan hormon testoteron pada pria. Nah, hal inilah yang bisa meningkatkan tingkat kesuburan seseorang meningkat. Hal yang sederhana namun berdampak luar biasa.
Meningkatkan Gerakan Limfatik

Selain bisa meningkatkan kesuburan, manfaat mandi pagi sebelum subuh lainnya adalah bisa membantu meningkatkan kinerja limfatik.
Yang dimaksud kinerja limfatik sendiri adalah gerakan sel darah putih dalam melawan berbagai infeksi serta virus yang ada dalam tubuh. Jadi jika kamu ingin terbebas dari berbagai macam penyakit, sering-seringlah mandi sebelum subuh.
Mengurangi Resiko Hipertensi

Manfaat mandi pagi sebelum subuh yang selanjutnya adalah bisa mengurangi resiko hipertensi. Selain itu, mandi sebelum subuh juga bisa menstabilkan kondisi emosinal seseorang sehingga bisa menjaga serta mengontrol tekanan darah tinggi.
Jadi jika kamu termasuk orang yang sering mengalami hipertensi, cobalah dari sekarang mulai membiasakan diri mandi sebelum subuh agar resiko terjadinya hipertensi semakin bisa berkurang.
Mengatasi Kejenuhan dan Depresi

Mengurangi Diabetes

Manfaat selanjutnya dari mandi sebelum subuh adalah bisa memberikan detoksifikasi pada tubuh. Adapun yang dimaksud detoksifikasi di sini adalah penstabilan kadar gula dalam darah yang dilakukan oleh suhu air yang dingin. Jadi bisa dipastikan jika kamu rutin mandi sebelum subuh, maka bisa menekan resiko terjangkitnya penyakit diabetes.
Demikian beberapa manfaat mandi sebelum subuh bagi kesehatan. Semoga kita bisa mulai membiasakannya ya supaya kesehatan kita bisa lebih terjaga. Semoga bermanfaat, sekian dan terima kasih.